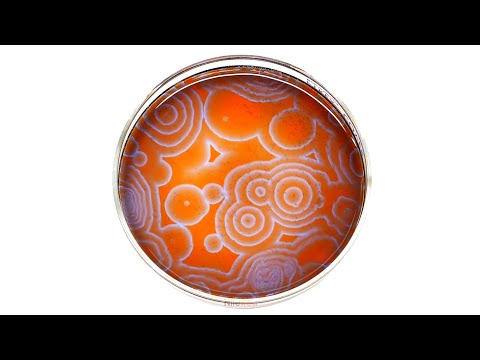

כל הסרטונים
כל רודפיה, חיזוק יומי | הרב צבי חלמיש שליט"א
צבי שלמה חלמיש (הרב)
משיבת נפש פרשת דברים עח | הרב צבי חלמיש שליט"א
צבי שלמה חלמיש (הרב)
הרב אייל עמרמי, חובת הלבבות שער הבטחון, ד' אב תשעח
הרב אייל עמרמי - הערוץ הרשמי
How to Replace Headlights 07-11 Honda CR-V
1A Auto: Repair Tips & Secrets Only Mechanics Know
React JS - מדריך React למתחילים
Programming with Mosh
פולקסווגן פולו - חוות דעת - iCar
אתר הרכב של ישראל - iCar
דברים חוצבי להבות על רבינו האריזל ממורינו הצדיק המקובל שר בית הזוהר הרב בניהו שמואלי שליט"א
ידידי ישיבת נהר שלום-המקובל הרב בניהו שמואלי
הספד על המקובל הצדיק הרב שריה דבילצקי זצוק"ל ממורינו המקובל שר בית הזוהר ר' בניהו שמואלי שליט"א
ידידי ישיבת נהר שלום-המקובל הרב בניהו שמואלי
תיקון תריס גלילה- איך מתקנים את התריס?
אתר מידרג
התקנת חלונות אלומיניום
אתר מידרג
רשתות נגד יתושים - כל הסוגים
אתר מידרג
איך להחליף רצועה בתריס?
אתר מידרג
הרב יגאל כהן לקראת תשעה באב | האהבה בינינו – היא זו שתנצח! [כתוביות]
הרב יגאל כהן - הערוץ הרשמי
בין המיצרים - הרב יחזקאל שלזינגר
הרב אהרן לוי
לביבות ירק ללא טיגון ללא גלוטן מתאים לצימחונים ..כמה קל ככה טעים ..תומר תומס בשר ברמה אחרת 💚
תומר תומס tomer tomas מתכונים